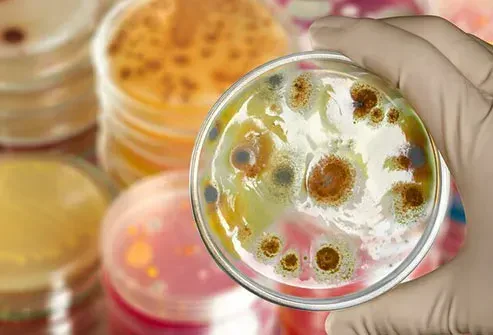

Oplysningerne På Webstedet Er Ikke Medicinsk Rådgivning. Vi Sælger Ikke Noget. Nøjagtigheden Af Oversættelsen Er Ikke Garanteret. Ansvarsfraskrivelse
MedikamenterSund levevis: Sundhedsfare, når du ikke vasker dine ark
Undercover -problemer

Du tilbringer en tredjedel af dit liv i sengen. Så ren sengetøj skal være et af dine must-do pligter. Tænk på den sved sved skæl og andre 'ting', du forlader mellem arkene. Ideelt set burde du hvidvaske dem ugentligt eller i det mindste hver anden uge. Men en nylig undersøgelse fandt, at amerikanere har en tendens til at være arkslakere, der går 25 dage mellem vaske.
Mite-y brutto

Du kaster 500 millioner hudceller om dagen. Mange slynger sig, mens du ruller rundt i sengen. Alle de døde celler hoper op på dine lagner mellem vask. Små støvmider elsker at fodre med skurcellerne. Critters og deres dråber kan udløse allergier astma og få dit kløende eksem til at blusse. Hvis du er allergisk over for støvmider, skal du vaske sengetøj hver uge i varmt vand.
Pet Peeves

Sover du med din pels baby? Rover eller Kittys hår og slib på dit strøelse bliver ekstra buffetpris for støvmider. Hvis din hund har en hudtilstand kaldet mange, der også kaldes Animal Scabies, kan du heldigvis ikke fange den fra ham, men din hud kan blive kløende og irriteret. Dine kæledyr kan også videregive en svampeinfektion kaldet ringorm i hovedbunden. Formålet at ændre dine ark en gang om ugen.
Bakterielle sengekammerater
Døde hudceller sved spyt og mere kan gøre din komfortable seng til en petriskål, så bakterier kan vokse. For eksempel fandt laboratorieundersøgelser, at vatpinde fra pillowcases uvasket i en uge indeholdt 17000 gange flere kolonier af bakterier end prøver taget fra et toiletsæde.
Soveværelsesudbrud

Er din acne værre, og du kan ikke finde ud af hvorfor? Din beskidte pudebetræk kunne være skylden. Den indlejrede snavs død hud og bakterier kan tilstoppe dine porer. Hvis du har dårlige udbrud, skal du ændre dine pudebetræk hver 2-3 dag og resten af dit strøelse en gang om ugen.
Syge ark

Hvis du eller din partner har været syg, kaster dine ark i vasken med det samme for at dræbe eventuelle dvælende bakterier. De fleste bakterier eller vira kan overleve på bløde overflader i minutter til timer. Varigheden varierer baseret på den specifikke mikrobe. For eksempel lever influenzavirus på væv i kun 15 minutter, men nogle mavefejl kan overleve på stoffer i 4 timer.
Hvad bruges zovirax salve til
Pude kast

Hvor du hviler på hovedet om natten kan være fuld af svamp - nogle kan være farlige for dem med astma. Hvis din pude - selve den fluffy ting - kan vaskes, gør det mindst to gange om året. Følg plejemærket om, hvordan man gør det. Sørg for at skylle og tørre det godt for at forhindre meldug. Hvis du bruger en pudebeskytter, skal du kaste den i vasken sammen med din pudebetræk.
Ark swaps

Nogle andre ting kan tilføje den icky faktor mellem dine ark. Strip sengen ugentligt (eller endnu oftere), hvis du:
Kan du tage Flexeril med Xanax
- Sov i nøgen
- Snack i sengen
- Sov med dine børn
- Sved meget om natten
Lad dine ark trække vejret

Du har måske hørt, at den bedste måde at sparke start din dag på er at lave din seng. Men det kan være klogt at ikke skynde sig. Det skyldes, at fugt bygger i dine lagner efter hver nat med sludder. Når du vågner op, skræl dækslerne tilbage og giver din seng en chance for at tørre. Det gør det til et mindre attraktivt hekkeplads for bakterier og mider.
Vask dagstips

Vugger dit sengetøj med det hotteste vand, der blev foreslået på plejemærket. Kast det derefter i tørretumbleren. Undersøgelser viser, at tørretumblerens varme kan dræbe nogle bakterier, der overlever vasken. Hvis det er sikkert for farven, skal du bruge en kimmorker som blegemiddel på dine ark, især hvis du renser op efter en syg person.
Beskidte dyner og mere

Nogle dyner eller dynebetræk ikke vaskbare maskine. Så tjek etiketter, før du hvidvask. Hold dig til denne rengøringsplan for et frisk soveværelse:
- Dyster tæpper og dynebetræk: en gang hver 1-2 måned. (Hvis du ikke bruger et øverste ark, skal du vaske dem, når du laver dine ark.)
- Madraspude: Vask fire gange om året
- Sengeskørt: Hver 3-6 måned
Bedbugs

Disse critters lokkes ikke af beskidte eller rene lagner. De er tiltrukket af dig. De bor på varme steder tæt på mennesker, så din seng er perfekt. Bedbugs gennemsøger om natten og fodrer med dit blod. Du vågner muligvis op med kløende bidmærker. Bugs rejser til dit hjem fra steder, der er angrebet som et hotel sovesal -værelses lejligheder skoler på dine jakker. Med andre ord-de er næsten overalt! Tør dit sengetøj på høj varme i 30 minutter for at dræbe bugs og deres æg.
Sund levevis: Sundhedsfare, når du ikke vasker dine ark
Kilder: 
Billeder leveret af:
- Demaerre / Getty Images
- Selvanegra / Getty Images
- Photoboyko / Getty Images
- Kunstnerer / Getty Images
- Penkanya / Getty Images
- Anne Boonkerdthinthai / Getty Images
- Webmd
- Mike Watson Images / Thinkstock
- VTT Studio / Getty Images
- MonkeybusinessImages / Getty Images
- Karammii / Getty Images
- John-Reynolds / Getty Images
Referencer:
- American Council on Science and Health: 'Husholdningsartikler, du aldrig renser, men bør.'
- American Cleaning Institute: 'Room by Room Cleaning Guide.'
- CDC: 'Scabies stillede ofte spørgsmål (ofte stillede spørgsmål).'
- Madras Advisor: 'En ren søvn: En undersøgelse af, hvor ofte amerikanere ændrer deres strøelse.'
- American Chemistry Society: 'Den tynde på, hvordan kaste hud reducerer indendørs luftforurening.'
- Cleveland Clinic: 'Her er hvor ofte du skal vaske dine lagner om sommeren - og de modbydelige grunde til, at' 'fnat' 'atleter fodjock kløe og ringorm i hovedbunden.'
- Amerisleep: 'Bakterier i din seng.'
- University of Kentucky: 'Husstøvmider.'
- American College of Allergy Asthma and Immunology: 'Støvallergi.'
- American Academy of Dermatology: '10 ting at prøve, når acne ikke rydder. '
- National Sleep Foundation: 'Hvor ofte har jeg virkelig brug for at vaske mit strøelse?'
- National Health Services (UK): 'Hvor længe lever bakterier og vira uden for kroppen?'
- Molly Maid: 'Hvor ofte skal du vaske dine ark?'
- Journal of Hospital Infektion: 'Hvidvaskning af hospitalets personaleuniformer derhjemme.'
- Infektionsøkologi
- New Mexico State University: 'At få tøj rent.'
- Allergi: 'Svampeforurening af strøelse.'
- Forbruger rapporterer: 'Hvordan man vasker en pude for at holde den lugtende frisk.'
- Merry Maids: 'Hvordan man vasker dine ark.'
- Miljøbeskyttelsesagentur: 'Bed Bug Myter' 'forberedelse til behandling mod sengebugs.'
- National Jewish Health: 'Forøgelse af din BEVERSE af sengebug.'
Dette værktøj giver ikke medicinsk rådgivning. Se yderligere oplysninger: 
Dette værktøj giver ikke medicinsk rådgivning. Det er kun beregnet til generelle informationsformål og adresserer ikke individuelle omstændigheder. Det er ikke en erstatning for professionel diagnose eller behandling af medicinsk rådgivning eller behandling og bør ikke være afhængig af at tage beslutninger om dit helbred. Ignorere aldrig professionel medicinsk rådgivning i at søge behandling på grund af noget, du har læst på RXList -webstedet. Hvis du tror, at du måske har en medicinsk nødsituation, skal du straks ringe til din læge eller ringe 911.
frivillige rejser
© 1996-2025 Webmd LLC . Alle rettigheder forbeholdes.
Kilde lysbilledshow på webmd
